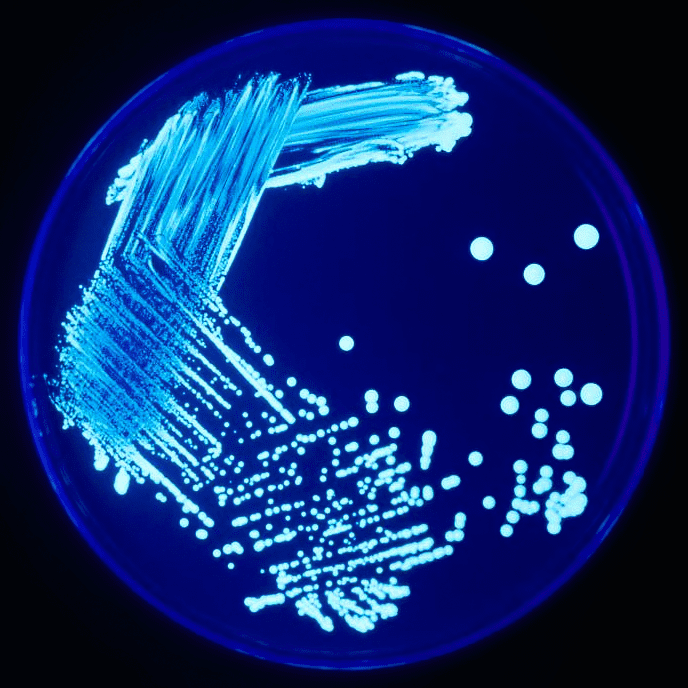

1372* 06 ottobre 2025
La legionella è un genere di batteri gram-negativi aerobi.
Le legionelle sono presenti negli ambienti acquatici naturali e artificiali: acque sorgive, comprese quelle termali, fiumi, laghi, fanghi, ecc.
Da questi ambienti esse raggiungono quelli artificiali come condotte cittadine e impianti idrici degli edifici, quali serbatoi, tubature, fontane e piscine, che possono agire come amplificatori e disseminatori del microrganismo, creando una potenziale situazione di rischio per la salute umana (Declerck et al., 2007; Fliermans et al., 1981). “Legionellosi” è la definizione di tutte le forme morbose causate da batteri Gram-negativi aerobi del genere Legionella. Essa si può manifestare sia in forma di polmonite con tasso di mortalità variabile tra 10-15%, sia in forma febbrile extrapolmonare o in forma subclinica. La specie più frequentemente coinvolta in casi umani è L. pneumophila anche se altre specie sono state isolate da pazienti con polmonite. I termini “legionellosi” e “Malattia dei Legionari”, vengono usati come sinonimo per indicare le forme morbose gravi (polmoniti) causate da microrganismi del genere Legionella. Dopo la prima identificazione nel 1976 (Fraser et al., 1977; McDade et al., 1979), si è osservato un po‟ ovunque nei Paesi industrializzati un notevole incremento del numero di casi e questo può essere attribuito sia al miglioramento degli strumenti diagnostici disponibili e alla maggiore sensibilità dei clinici nei confronti della malattia, sia all‟aumento delle occasioni di esposizione all‟agente eziologico dovuto all‟incremento del turismo, della frequentazione di centri-benessere e alla sempre più diffusa installazione di impianti di condizionamento centralizzati negli ambienti ad uso collettivo, dotati di torri di raffreddamento e/o condensatori evaporativi. Essendo il microrganismo ubiquitario, la malattia può manifestarsi con epidemie dovute ad un‟unica fonte con limitata esposizione nel tempo e nello spazio all‟agente eziologico, oppure con una serie di casi indipendenti in un‟area ad alta endemia o con casi sporadici senza un evidente raggruppamento temporale o geografico. Focolai epidemici si sono ripetutamente verificati in ambienti collettivi a residenza temporanea, come ospedali o alberghi, navi da crociera, esposizioni commerciali, ecc. I casi di polmonite da Legionella di origine comunitaria si manifestano prevalentemente nei mesi estivo-autunnali, mentre quelli di origine nosocomiale non presentano una particolare stagionalità.
Sono disponibili le “Linee guida per la prevenzione ed il controllo della legionellosi”.
Consultateci.
Vuoi saperne di più? Scrivici senza impegno!